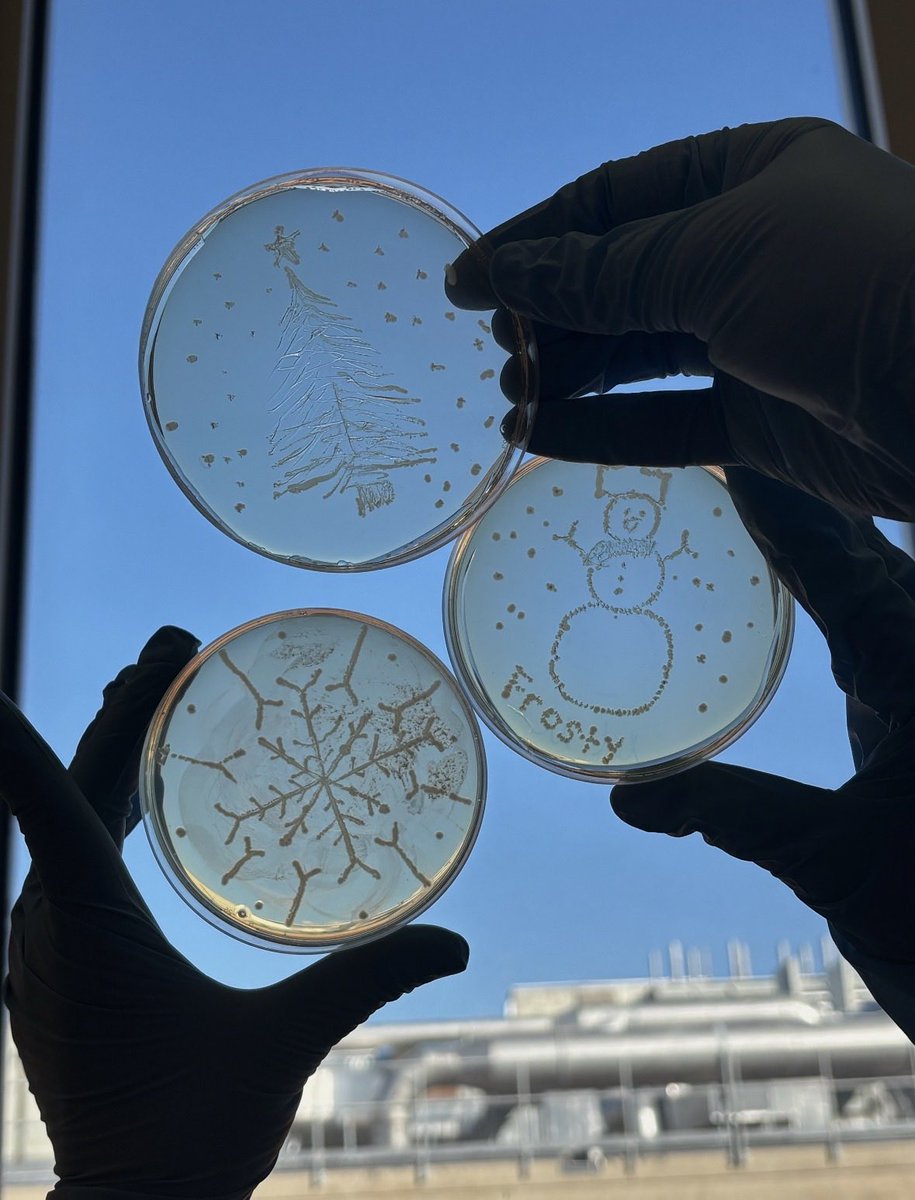
Wen Zhu Lab tweet media

Wen Zhu Lab
59 posts


Wen Zhu Lab
@WenZhu_Lab
Wen Zhu Lab @ChemistryFSU | Translational Enzymology & Drug Discovery | Student-run account
Tallahassee Katılım Ocak 2023
64 Takip Edilen27 Takipçiler

New preprint! We report the characterization of a radical SAM enzyme in the bacterial pathogen, Moraxella catarrhalis. A fantastic collaboration with the Britt Lab and de Crécy-Lagard Lab. biorxiv.org/content/10.648…
English

February is Rare Disease Month 💜 In collaboration with @LabTakagi, we show that conformational remodeling underlies activity loss in an asparagine synthetase variant causing asparagine synthetase deficiency, a rare neurometabolic disease.
👉 biorxiv.org/content/10.648…
#RareDisease
English

A fire at the Seminole Social apartment complex has left some PhD students at Florida State University without a home. Please consider donating or sharing to support them during this difficult time. Thank you for your kindness and generosity. gofund.me/ab3fba3b8
English
Wen Zhu Lab retweetledi

Wen Zhu, Ph.D. from the Department of Chemistry and Biochemistry (@chemistryfsu) presented “Identifying a Tunnel-Gating Residue in Human Asparagine Synthetase” at the American Chemical Society’s Florida Annual Meeting and Exposition in Palm Harbor. 🧪🧑🔬🧬
#FSU #FSUFaculty

English

#RareDiseaseThursday Mutations in SMPD1 disrupt acid sphingomyelinase, leading to Niemann-Pick disease type A, a devastating lysosomal storage disorder. Lipids accumulate in cells, causing neurodegeneration, hepatosplenomegaly, and failure to thrive in infancy.

English
Wen Zhu Lab retweetledi

It's National Chemistry Week! 🧪 To celebrate, @FloridaState graduate students are hosting an event on Saturday, Oct. 25, at the Dr. B.L. Perry Jr. Branch Library from 10-11:30 a.m., featuring science demonstrations and hands-on activities for kids and families!

English

Check out our latest preprint on an unexpected mechanism of a potent ASNS inhibitor: Cryo-EM reveals how ASX-173 inhibits human asparagine synthetase to activate the integrated stress response biorxiv.org/content/10.110…
English

Passionate about enzyme structure, function, and dynamics, and applying that knowledge to drug discovery? 💊🧬🧫🧪 We’re recruiting a Postdoc!
Come join us! Apply: wzhulab.com/contact
#PostdocJobs #Biochemistry #Enzymology #Metalloenzymes #ProteinDynamics
English

Today in our #RareDiseaseThursday spotlight: Argininosuccinate synthetase deficiency (ASSD), a urea cycle disorder caused by pathogenic variants in ASS1, impairing the conversion of citrulline+aspartate to argininosuccinate. This leads to long-term neurological damage.

English
Wen Zhu Lab retweetledi

.@ChemistryFsu's Brian Miller, Michael Shatruk, Fanny Caroline Liu, and Wen Zhu are all recognized in @FloridaState's September 2025 Faculty and Staff Briefs!
Florida State University@FloridaState
Congratulations to these Florida State University faculty and staff members who are earning recognitions across the country and around the world! 🌟 #FSUFaculty 🔗 Read more at fla.st/Y1HVBCD6
English

Congrats Wen! 🎉🎉➡️FSU chemist earns $2.1 million NIH grant to investigate molecular causes of disease: news.fsu.edu/news/science-t…
English